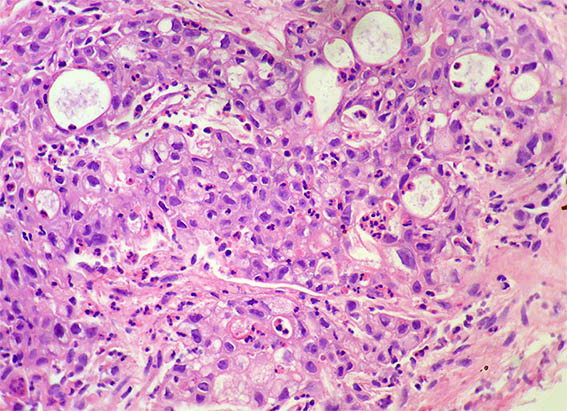
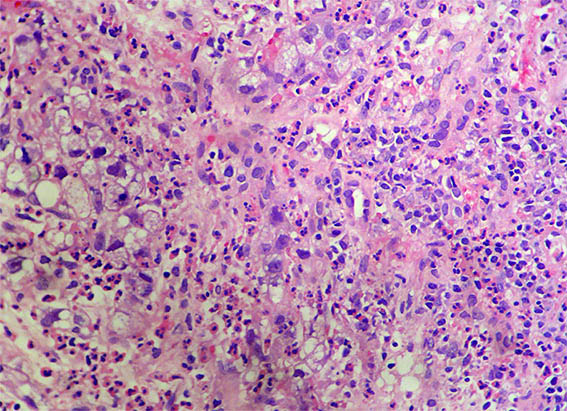
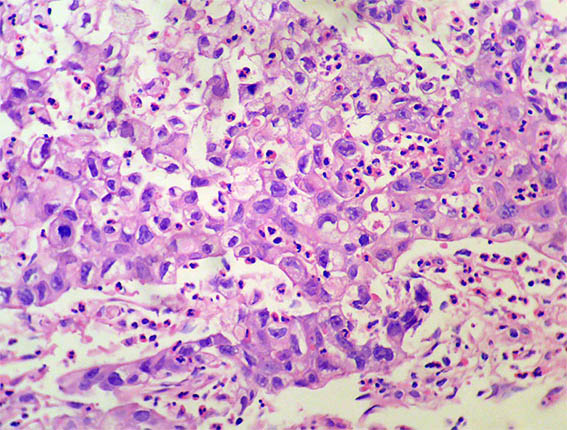

|
|
CASO
207(mayo de 2023)
Datos clínicos:
Una niña de 12 años es evaluada por presentar dolor abdominal casi constante, de 10 días de evolución. Al examen físico se palpa masa en flanco izquierdo. Hay microhematuria. Por ecografía se detecta masa renal de 14 cm, reemplazando en gran parte el riñón izquierdo. En estudio de tomografía no se identifican otras lesiones toracoabdominales. La niña presenta crecimiento y desarrollo normales. Hay historia familiar de anemia de células falciformes. Hemoleucograma normal.
Se hace biopsia de la masa renal.

Figura 1. H&E, X100.

Figura 2. H&E, X100.

Figura 3.
H&E, X100.
Figura 4. H&E, X200.

Figura 5. H&E, X200.

Figura 6. H&E, X200.
Figura 7. H&E, X400.
Figura 8. H&E, X400.

Figura 9. H&E, X400.

Figura 10. H&E, X400.

Figura 11. Inmunohistoquímica para cóctel de citoqueratinas, X400.

Figura 12. Inmunohistoquímica para INI1 / SMARCB1, X400. Negativa en las células neoplásicas.
Inmunomarcación para WT1, S100, ALK, ACL, ciclina D1, BCOR, TFE3 y TFEB: Negativas.
¿Cuál es su diagnóstico?
Ver
diagnóstico y discusión
[Arriba]
|
|